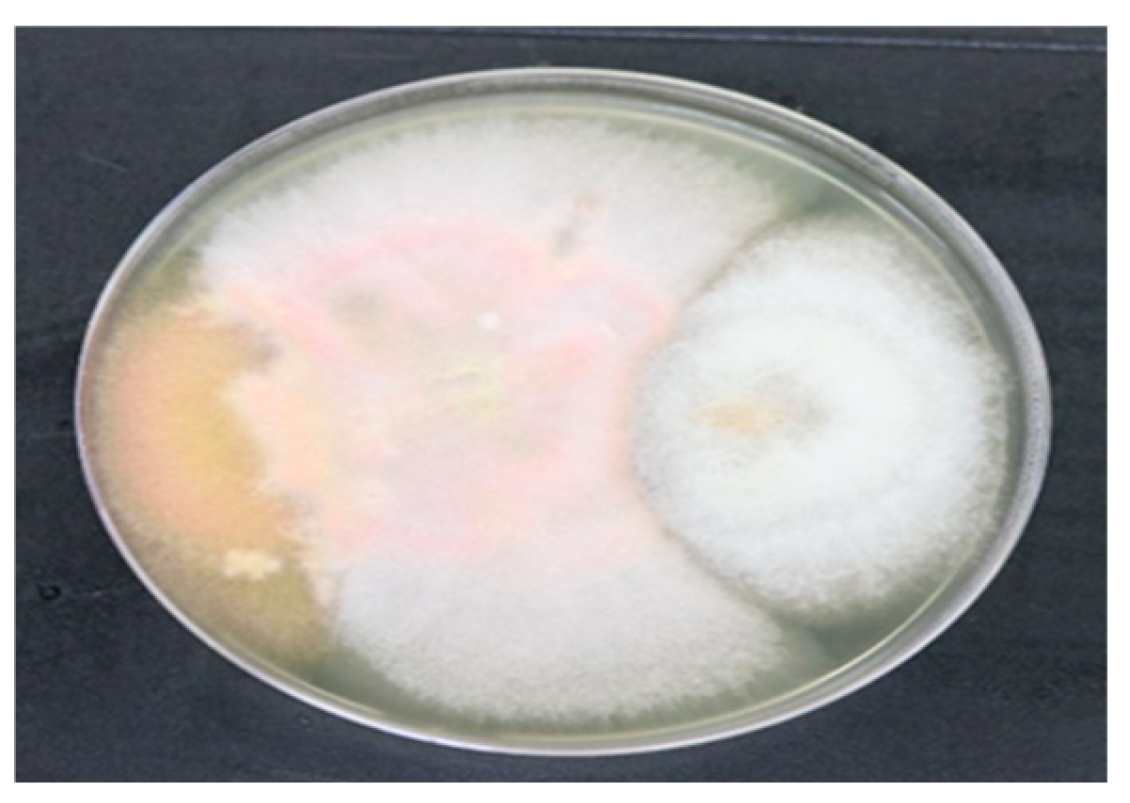
Preprints 138418 g004

1. Introduction
1.1. Fungal Endophytes
All plant species investigated to date have endophytes;-, however, the majority of the connections between endophytes and plants are still poorly understood. Certain endophytes can improve a plant's capacity to withstand abiotic stressors, such as drought, and reduce biotic stressors, such as insects and disease resistance. They can also boost the host growth and nutrient uptake [
1]. In nature, endophytes play a vital role in protecting plants from diseases, herbivores, and heat stress by inhibiting the growth of grasses and other plants. They can act as biocontrol agents and encourage plant growth and productivity. The primary function of endophytic organisms in the advancement of plant development is their capacity to inhibit plant tissues, and their close proximity to one another within plant tissues promotes the exchange of nutrients and enzyme activity [
2,
3]. Fungi are inhibited, prevented, and destroyed, and their proliferation is limited by their antifungal activity.
It is a pharmaceutical, fungistatic, or antifungal drug used to treat and prevent major systemic infections, athlete's foot, ringworm, candidiasis (thrush), and other mycoses [
4]. Because many of the metabolic processes that plants engage in are induced or indirectly regulated by microbes, the relationships that exist between plants and microorganisms in the rhizosphere or within the plant itself are crucial. We are currently investigating whether endophytes can help manage harmful fungi through such interactions.
1.2. Fungal Endophytes
As a staple in the human diet, cabbage is a rich source of phytochemicals that provide chemoprotection. Overall, six major cabbage diseases were identified: wire stem, watery delicate decay (white form), fleece build-up, club roots, dark spots (dim spots), and dark ruins. Seed-borne diseases can cause dark rot and dark spots. The pathogens responsible for club roots, watery delicate waste, and wire stems are soil-borne; the life form of club root is extraordinarily difficult to eradicate from infected soils. The main obstacle preventing lucrative commercial cabbage farming in India is the cabbage diseases. Important management strategies include treating the seeds with high-temperature water or applying fungicides. Black leg, black-rot, and cabbage yellows were the most damaging symptoms. Anybody might destroy more, A crop can be destroyed by anyone in larger quantities [
11,
12], respectively:
1.3. Pathogenic fungi
Approximately 100,000 fungi have been identified to date, many of which receive nutrition by coexisting closely with other organisms.-, Pathogenic fungi cause a wide range of diseases in humans and other living organisms, and there are several types of fungi that are harmful to humans and can cause major economic losses due to disease outbreaks in animals or contaminated crops.
Approximately 300 fungi have been identified to be harmful to human [
3]. The environment is affected by pathogenic fungi, both directly and indirectly. The form and character of vegetation in plant networks and biological ecosystems might be greatly impacted by fungal infections, for instance, by decreasing the rate of development and increasing the vulnerability to other pests. Infecting fruits, seeds, and inflorescences, many have an impact on plant capacity to reproduce. Their ability to fend off illness affects the genetic diversity of their hosts [
13].
1.4. Antifungal Activity
Antifungal activity inhibits, prevents, and destroys fungi, and limits their growth. It is an antifungal medication, pharmaceutical fungicide, or static fungus used to treat and prevent mycosis, such as athlete's foot, ringworm, candidiasis (thrush), and serious systemic infections [
4].
2. Materials and Methods
The cabbage plant samples were collected from farms and market [2-2]. The samples were purchased in the laboratory in separate sterilized polythene bags. Potato dextrose media(PDA) and yeast malt agar (YMA) were used. Isolate pathogens. The layers of the cabbage leaves were cut into very small pieces using sterilized blade. The mixture was washed with distilled water. The pieces were then placed directly in-to the medium using forceps. The cells were incubated at 28 ͦ C for at least 2 weeks. Endophyte isolation, The leaf layers s were cut into small pieces using sterilized blade. The mixture was washed thrice with distilled water. The samples were dipped in 70% ethanol for 1 min. The leaf pieces were washed thrice with sodium hypocrite. The samples were washed again with distilled water. They were cut into very small pieces. Small pieces of leaves were placed in media containing plates. The samples were incubated at 28 ͦ C for at least 2 weeks. To obtain a pure culture after 10 d of incubation, visible growth was observed on the plates. The mixed colonies were then separated into new plates. The plates were then incubated at 28 ͦ C for growth. Isolation of genomic DNA by the Edward Method [
5]. Sequencing of the purified Polyethylene Glycol product was performed using a sequencer. Sanger sequencing was used for sequencing. The assays were performed in 96 well plates [
2]. Pathogenicity tests were performed using the dual culture method; in fresh PDA media plates, both the pathogenic fungi and fungal endophytes were kept opposite to one another, and the identity was marked with the marker. The culture plate at 28⁰C for 1 week. The plate was checked’ every day-, as the pathogens showed faster growth [
3].
3. Results
3.1. Identification, Collection of Endophytes & Pathogenic Fungi
Samples collected from market areas showed more fungal contamination after isolation than agricultural field (farm) samples. Fungal growth was observed in pure culture plates after 11-12 days of incubation at 28 ͦ C incubator. Out of 60 isolated fungi, 52 fungi were identified, of which most fungi’s showed the morphology of Aspergillus species (
Figure 2) and Fusarium species (
Figure 1). In addition, four pathogenic fungi from these two species were identified based on their morphological structure (
Figure 1 and
Figure 2).
3.2. Antifungal Activity
By carrying out this proces of antifungal testing, by dual plate method positive results wew observed (
Figure 3 and
Figure 4). Pathigenic fungi Aspergillus niger, Aspergillus fumigatus, Fusarium graminearum, Fusarium oxysporum. The fungal endophytes Fusarium luffae, Curvularia aeria, Collectitrichum aciculare, Trichoderma longibrachiatum, and Trichoderma eukandiense were maintained in a media plate, showing that endophytes inhibit the pathogens.
Curvularia aeria and
Tricoderma eukendience showed greater inhibition than the other three fungus (
Figure 5).
4. Discussion
This study provides an overview of the effects of endophytic fungi on pathogenic fungi isolated from cabbage. The four samples collected from two different types of areas, that is., agricultural fields and marketplaces, were isolated and provided us with different results, showing different types of various varieties of pathogenic fungi and endophytes. The results showed that the sample collected from the market area had more fungal growth than the agricultural field.
After isolating the pure culture of different fungi from a mixed culture of four different areas, 55 plates showed sporulation and five plates showed spore formation. The morphological identification of these plates predominantly showed the presence of four pathogenic fungi that could be identified microscopically:
Aspergillus niger (
Figure 2),
Aspergillus fumigators, Fusarium oxysporum, and Fusarium graminearum.(
Figure 1)
Molecular identification was performed by DNA isolation, followed by agarose gel electrophoresis. The positive results of the polymerase chain reaction (PCR) products, which show the presence of three DNA fragments, displayed results in the polyethylene glycol (PEG) procedure. The five samples showing the presence of DNA bands were analyzed by Sanger Sequencing. The results of sequencing decoded by BLAST software identified endophytes, such as
F. luffae, Curvularia aeria, Colletotrichum aciculare, Trichoderma longbrachium, and Trichoderma eukadiense. (
Figure 6)
The pathogenicity test usim[nh the dual-plate method-, depicts the antifungal activity of the endophytic fungi on pathogenic fungi. The effectiveness of the endophytes against pathogenic fungi was rated according to the size of the zone of inhibition. The zone of inhibition represents the effectiveness of endophytes on pathogenic fungi by restraining their growth through metabolic processes. All five endophytes inhibited the growth of pathogenic fungi.
As shows in
Table 1, the effectiveness of different endophytes displayed varying results on all the identified pathogenic fungi. The effect of endophytes on
Aspergillus niger indicates the maximum rating, that is, 5 is
Curvularia aeria, followed by
Trichoderma eukadiense, which shows a rating of 4, Indicating that these two endophytes have the maximum effect on
Aspergillus niger, while the rest show minimal inhibition.
The effect of endophytes on
Aspergillus fumigatus indicates that
Trichoderma longibrachiatum and
Colletotrichum aciculare showed the minimal rating of inhibition, that is, 1 for both. The highest inhibition was observed for
Curvularia aeria by
Trichoderma eukadiense, which had a rating of 5.(
Figure 5)
The effect on
Fusarium graminearum by endophytes indicates that all the endophytes have some effects on the pathogenic fungi, which shows the variations in ratings that is
Trichoderma eukadiense shows the maximum rating of 5, followed by
Curvularia aeria with rating of 4,
Trichoderma longibrachiatum 3,
Colletotrichum longibrachiatum 2, and
Fusarium Luffae with 1.(
Figure 5)remained to edit
The effect on Fusarium oxysporum by endophytes indicates the maximum inhibition is shown by
Curvularia aeria and
Trichoderma eukadiense with rating of 5 and 4 followed by
Colletotrichum aciculare and
Trichoderma longibrachiatum with rating of 2. (
Figure 5)
Observations shows that
Curvularia aeria,
Trichoderma eukadiense and
Trichoderma longibrachiatum shows the maximum zone of inhibition in all four pathogenic fungi whereas
Fusarium luffae and
Colletotrichum aciculare shows minimal inhibition. (
Figure 3 and
Figure 4)
The second major problems faced by farmers is fungal diseases vastly affecting vegetables and there are no such pesticides known for treating fungal diseases. Farmers are suffering from high losses in the agricultural field because of this fungal infection especially in the cultivation of cabbage. The solution to this problem is natural pesticides which does not has any adverse effect to the environment.
This project highlights the endophytes which can act as an antifungal agent against pathogenic fungi which were isolated from cabbage can further play a significant role in the composition of bio or organic pesticides. Also the two probable novel endophytes that is
Curvularia aeriaand
Trichoderma eukadiense (Figure 3 and Figure 4) found during this study.
Author Contributions
S.S. Gate, the author, contributed to the project's conception and design of the experiments as well as the interpretation of the data and critical revision of all the data obtained from the experiments and literature that were collected for this work's intellectual content. V.A. Dhore and S.S. Gate also contributed to the drafting of paper. M.A. Dhotre, the author, participated in the analysis of the experiment data.
Funding
There was no outside support for this Research.
Data Availability Statement
There is no data anywhere, and more work is being done.
Acknowledgments
I would like to thank Sachine Kulkarni to allow me to carry out my research work at Rajarshi Shahu Mahavidyalaya Latur (Autonomous).and also thank to him, for his expert suggestions, guidance and encouragement throughout the course of my project and for providing me all the laboratory facilities required to complete my project.
Conflicts of Interest
The authors declare no conflict of interest.
References
- Jahani S, Bazi S, Shahi Z, Sheykhzade Asadi M, Mosavi F, Sohil Baigi G. Antifungal Effect of the Extract of the Plants Against Candida albicans. Journal of Infect 2016,4(2).
- Suryanarayanan. TS. Fungal Endophytes: An Eclectic Review. Journal of KAVAKA . Journal of Plant Mol Biol,2017,48(1),1-9.
- Busby PE, Ridout M, Newcombe G. Fungal endophytes: modifiers of plant disease. Journal of Plant Mol Bio,2016,90(16),645-55. [CrossRef]
- Lorito M, Harman GE, Hayes CK, R.M. B. Chitinolytic Enzymes Produced by Trichoderma harzianu :Antifungal Activity of Purified Endochitinase and Chitobiosidase. Journal of molecular plant pathology,1992,83(3),1-6.
- Bhale UN. Survey of market storage diseases of some important fruits of Osmannabad District (M. S.) India. journal of Science Research Reporter,2011,1(2),88-91.
- Vidhyasekaran P. Fungal Pathogenesis in Plants and Crops: Molecular Biology and Host Defense Mechanisms. Journal of Boca Raton,2007.
- Tamari F, Hinkley CS, Ramprashad N. A Comparison of DNA Extraction Methods using Petunia hybrida Tissues. Journal of Biomol Tech JBT,2013,(24)13,113-118. [CrossRef]
- Choi Y-J, Shin H-D, Hong S-B. Morphological and molecular discrimination among Albugo candida materials infecting Capsella bursa-pastoris world-wide. Journal of Fungal Divers,2007, 24,11-34.
- Nacsa-Farkas E, Kerekes E, Kerekes EB, Krisch J, Roxana P, Vlad DC, et al. Antifungal effect of selected European herbs against Candida albicans and emerging pathogenic non-albicans Candida species. Journal of Acta Biologica Szegediensis,2014, 58(1),61-64.
- Helmerhorst EJ, Troxler RF, Oppenheim FG. The human salivary peptide histatin 5 exerts its antifungal activity through the formation of reactive oxygen species. Journal of Proc Natl Acad Sci,2001, 98(25),14637–42. [CrossRef]
- Tjitraresmi A, Kusuma SAF, Rusmiati D. Cabbageleaf Extract(Brassica Oleracea Var. Capitata Alba) As A Herbal Medicine For Leucorrhea. Asian Journal of Pharm Clin Res,2017, 10(14)39.
- Sharma A, Rathore J. Major diseases and pathogen ecology of cabbage. The Pharma Innovation Journal,2018, 7(7)574-578.
- Kumar A, Jaiswal AK. Capacity Building Programme on Scientific Lac Cultivation, Processing, Uses and their Correlates. In the journal of Indian Research Journal of Extension Education, (2015). 15(1)60-64.
|
Disclaimer/Publisher’s Note: The statements, opinions and data contained in all publications are solely those of the individual author(s) and contributor(s) and not of MDPI and/or the editor(s). MDPI and/or the editor(s) disclaim responsibility for any injury to people or property resulting from any ideas, methods, instructions or products referred to in the content. |
© 2024 by the authors. Licensee MDPI, Basel, Switzerland. This article is an open access article distributed under the terms and conditions of the Creative Commons Attribution (CC BY) license (http://creativecommons.org/licenses/by/4.0/).